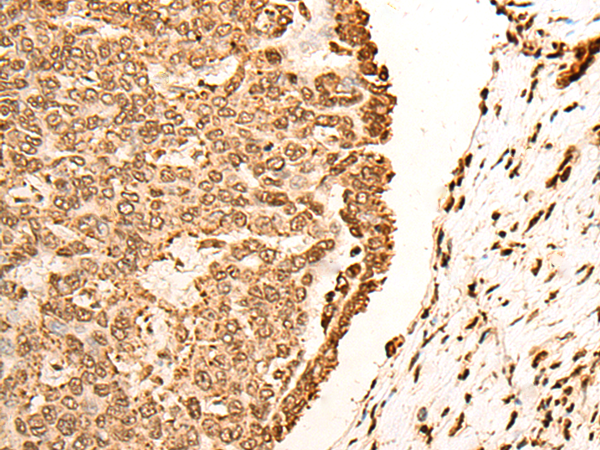

中文名稱: 兔抗H2BC1多克隆抗體
英文名稱: Anti-H2BC1 rabbit polyclonal antibody
別 名: H2B clustered histone 1; STBP; TH2B; H2BFU; TSH2B;
相關類別: 一抗
抗 原: H2BC1
儲 存: 冷凍(-20℃)
宿 主: Rabbit
反應種屬: Human, Mouse, Rat
標 記 物: Unconjugate
克隆類型: rabbit polyclonal
Background:
Histones are basic nuclear proteins that are responsible for the nucleosome structure of the chromosomal fiber in eukaryotes. Nucleosomes consist of approximately 146 bp of DNA wrapped around a histone octamer composed of pairs of each of the four core histones (H2A, H2B, H3, and H4). The chromatin fiber is further compacted through the interaction of a linker histone, H1, with the DNA between the nucleosomes to form higher order chromatin structures. This gene is intronless and encodes a replication-dependent histone that is a testis/sperm-specific member of the histone H2B family. Transcripts from this gene contain a palindromic termination element. [provided by RefSeq, Aug 2015]
Applications:
ELISA, WB, IHC
Name of antibody:
H2BC1
Immunogen:
Synthetic peptide of human H2BC1
Full name:
H2B clustered histone 1
Synonyms:
STBP; TH2B; H2BFU; TSH2B; hTSH2B; TSH2B.1; HIST1H2BA; bA317E16.3
SwissProt:
Q96A08
IHC positive control:
Human esophagus cancer and Human liver cancer
IHC Recommend dilution:
30-150
WB Predicted band size:
14 kDa
WB Positive control:
TM4, A549 and PC-3 cell, Human prostate tissue and Mouse adipose tissue lysates
WB Recommended dilution:
200-1000
技術規格

購物車
幫助
021-54845833/15800441009
